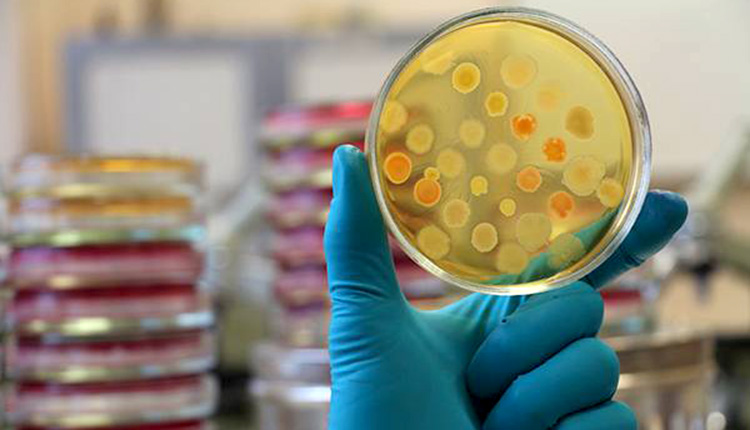

Ενώ μέχρι τώρα στην Κρήτη όλα τα ύποπτα κρούσματα που έχουν εξεταστεί στα εργαστήρια Ιολογίας του Πανεπιστημίου Κρήτης είναι “καθαρά” από κοροναϊό, οι μονάδες υγείας προετοιμάζονται καθημερινά για τη διαχείριση και νοσηλεία περιστατικών, όταν αυτά κάνουν την εμφάνισή τους.
Σύμφωνα με τα όσα είπε στην “Π” η διοικήτρια της 7ης ΥΠΕ Κρήτης Λ. Μπορμπουδάκη, τις επόμενες ημέρες τα νοσοκομεία στελεχώνονται με επικουρικό νοσηλευτικό προσωπικό, ώστε να ενισχυθούν τα ΤΕΠ, αλλά και να ανοίξουν κλειστά κρεβάτια Εντατικής Θεραπείας. Επιπλέον, υπάρχει σχεδιασμός για την εκκένωση κλινικών – αν χρειαστεί – για να νοσηλευθούν ασθενείς που έχουν προσβληθεί από τον ιό.
“Δεν χρειάζεται να τρομάζουμε, χρειάζεται να προετοιμαζόμαστε σωστά για όλα τα ενδεχόμενα”, τόνισε.
Αλλωστε, οι ειδικοί τονίζουν ότι το επόμενο διάστημα αναμένεται ραγδαία αύξηση των κρουσμάτων και περισσότερο ευάλωτοι είναι οι άνθρωποι με χρόνια νοσήματα και οι ηλικιωμένοι.
Ποια άτομα ανήκουν στις ευπαθείς ομάδες
Ηλικιωμένοι και τα άτομα με υποκείμενα νοσήματα (όπως σακχαρώδη διαβήτη και καρδιαγγειακά νοσήματα, χρόνια αναπνευστικά νοσήματα, κακοήθειες, ανοσοκατασταλμένοι) είναι περισσότερο ευάλωτοι να νοσήσουν σοβαρά, εφόσον προσβληθούν από τον νέο κοροναϊό.
Βάσει των μέχρι τώρα επιστημονικών δεδομένων, η σοβαρή νόσηση αφορά κυρίως σε ασθενείς ηλικίας μεγαλύτερης των 50 ετών, ενώ τα περισσότερα θύματα είναι άνω των 60 ετών και είχαν άλλα συνυπάρχοντα προβλήματα υγείας, όμως υπήρξε και η περίπτωση θανάτου ενός νεαρού υγιούς ατόμου.
Τι να κάνουν οι ευπαθείς ομάδες για να προστατευθούν;
Για τις ευπαθείς ομάδες του πληθυσμού κρίνεται ιδιαίτερα αναγκαία η συστηματική εφαρμογή όλων των μέτρων για την πρόληψη της μετάδοσης και διασποράς του νέου κοροναϊού, με έμφαση στα ακόλουθα:
– Αποφυγή επαφής με άτομα με συμπτωματολογία λοίμωξης του αναπνευστικού συστήματος.
– Αποφυγή όλων των μη απαραίτητων ταξιδιών, ιδιαίτερα σε περιοχές ή χώρες με επιβεβαιωμένη μετάδοση του ιού στην κοινότητα.
– Εφαρμογή της υγιεινής των χεριών και αποφυγή επαφής των χεριών με το πρόσωπο (μάτια, μύτη, στόμα).
– Συμμόρφωση στη χρόνια φαρμακευτική αγωγή που ενδεχομένως λαμβάνουν και στις οδηγίες των θεραπόντων ιατρών.
– Αποφυγή χώρων συγχρωτισμού και εκδηλώσεων εκτός αν είναι απαραίτητο.
– Άμεση επικοινωνία με τον θεράποντα ιατρό σε περίπτωση εμφάνισης συμπτωμάτων λοίμωξης του αναπνευστικού συστήματος και ιατρική αξιολόγηση.
– Αποφυγή επισκέψεων σε νοσηλευόμενους ασθενείς.
– Αποφυγή επισκέψεων σε χώρους υπηρεσιών υγείας χωρίς σοβαρό λόγο.